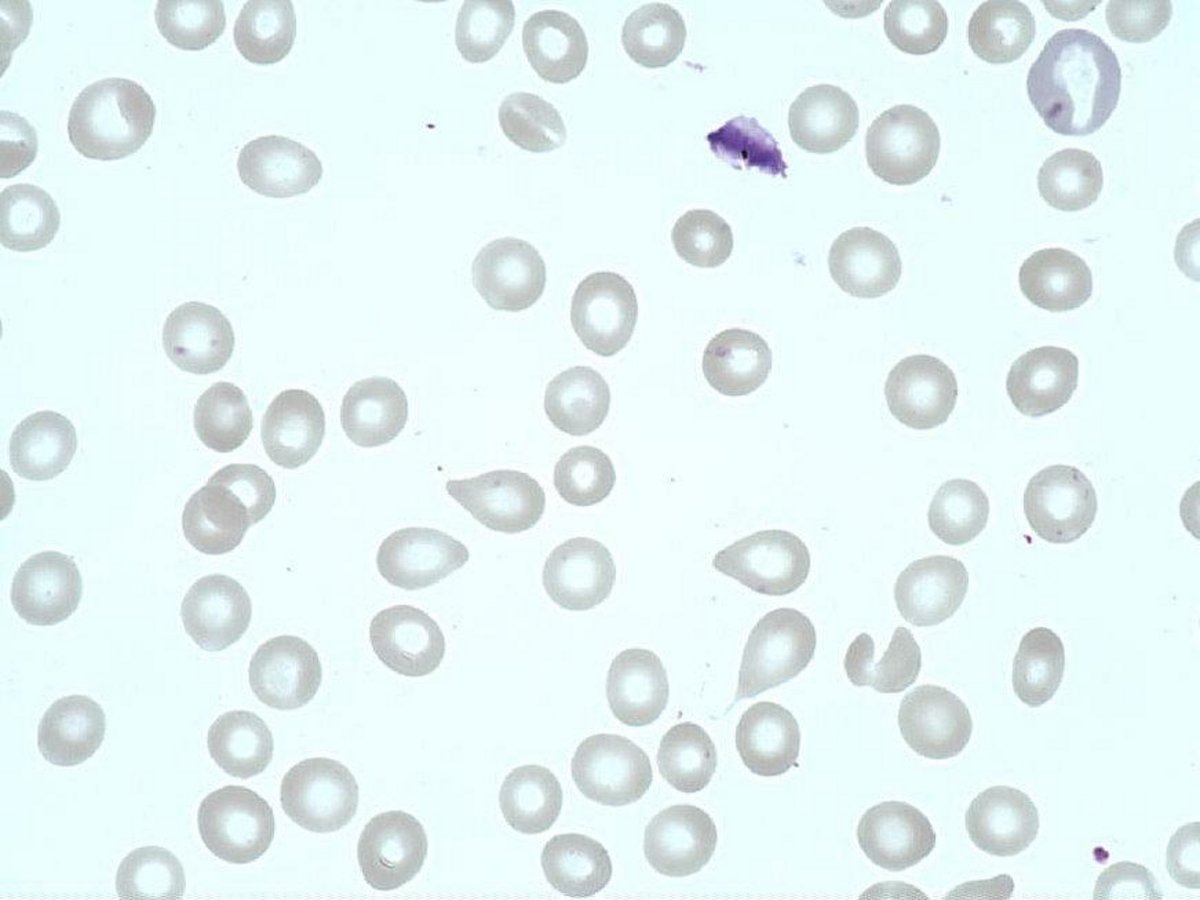
Tear_drop_cell__dacryocyte_

Tear drop cell (dacryocyte)
- Size : N/A
- Normal values : Absent in the blood
- Description / Pathology :
Red blood cells with extension tapered at one end, shaped like a tear or a pear (Teardrop RBC )
Myelofibrosis, various dyserythropoïesis.
Red blood cells with extension tapered at one end, shaped like a tear or a pear (Teardrop RBC )
Myelofibrosis, various dyserythropoïesis.